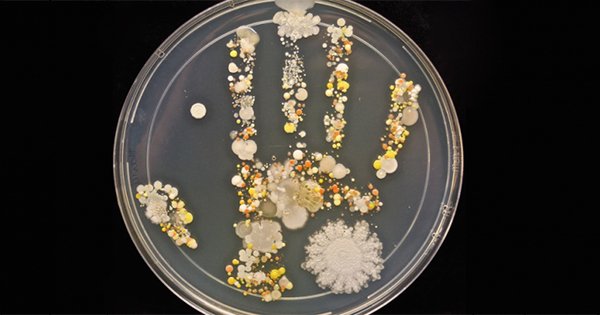
Этот отпечаток руки взорвал Интернет. Теперь я буду мыть руки как можно чаще…

В повседневной жизни нам время от времени под руку попадаются горячие предметы: раскаленная сковорода, чайник с кипятком или просто включенный утюг. Поэтому, к сожалению, бытовые ожоги — не редкость. Но мы даже не догадываемся, что получить сильный ожог можно и […]
Метка: Гигиена
Когда врач увидел зубы 3-летнего ребенка, он задал матери всего один вопрос…
Более 93 % людей разного возраста страдает от кариеса зубов! Мы знаем об этом заболевании очень много, но вместе с тем недостаточно… Чтобы у взрослого человека не возникло кариеса, нужно проводить профилактику еще в детстве. К сожалению, одной регулярной чисткой […]
42 секунды: столько времени понадобится, чтобы сделать руки безупречно чистыми!
Вот что мы делаем всей редакцией, чтобы не болеть в осенне-зимний период: моем руки правильно! Оказывается, есть несколько моментов, на которые нас не учили обращать внимание в детстве. Чтобы удалить все болезнетворные микроорганизмы с поверхности кожи рук, необходимо обязательно следовать […]
Что поможет перестать мыть унитаз каждый день
Как хорошо всегда иметь под рукой эффективное средство для поддержания чистоты и свежести в туалете! «Так Просто!» предлагает изготовить своими руками шипучие бомбочки для унитаза. Много времени это не займет, зато ты существенно сэкономишь на покупке бытовой химии. Это средство моментально […]
Если молочница была хотя бы один раз! Важно учитывать всем женщинам после 30.
Диета в лечении молочницы — ключевой момент! Кандидоз, эту пренеприятнейшую грибковую инфекцию невозможно победить полностью без поддержания здоровой среды в организме. Правильное питание будет хорошей профилактикой молочницы у женщин, которых она систематически мучает. Чтобы ограничить рост и развитие грибка Candida, […]
17 вещей, которыми НИКОГДА не стоит делиться. Вовремя обрати внимание!
Наверняка с каждым случались ситуации, когда приходилось одалживать близким людям личные вещи. Вроде понимаешь, что это неправильно, но и отказать неудобно. Некоторые из этих безобидных вещей могут нанести непоправимый вред организму! Даже если ты полностью уверен в человеке, которому даешь […]
Смешав всего 3 ингредиента, ты навсегда забудешь о запахе пота!
Согласись, что покупные дезодоранты не всегда оправдывают наши ожидания. Более того, антиперспиранты содержат вещество, которое закупоривает потовые железы, нарушая их нормальное функционирование. Но без этого косметического средства в современном мире не обойтись. Как говорится, если хочешь сделать что-то хорошо — […]
Врачи бьют тревогу: чистка ушей ватными палочками может быть опасной для здоровья!
Многие из нас используют ватные палочки для чистки ушей. Это очень удобно и гигиенично, по нашему мнению. Но всё больше врачей выступают против регулярных чисток этим приспособлением. Причин этого они называют массу и советуют очень осторожно относиться к подобным вещам, […]
Как избежать заражения грибком стопы: важно знать всем, кто собрался в отпуск!
Грибок на ногах — очень распространенное заболевание, а всё потому, что заразиться им довольно легко. У этой инфекции много неприятных признаков, и все они отрицательно сказываются на качестве жизни людей. Но меры предосторожности против заражения этой болячкой до сих пор не […]
Этот отпечаток руки взорвал Интернет. Теперь я буду мыть руки как можно чаще…
Наш организм является домом для огромного количества микробов и бактерий, но без микроскопа их увидеть невозможно. Хотя это, наверное, даже к лучшему, что мы не можем видеть весь этот ужас. Сколько микробов на наших руках Недавно Интернет облетел снимок силуэта […]
5 лучших рецептов натуральной зубной пасты своими руками. Откажись от химии!
Каждый из нас с детства знает, зачем нужно чистить зубы. С каждым годом на полках магазинов появляется всё больше и больше видов зубных паст. Производители добавляют в них агрессивные компоненты, которые вредны для здоровья не только зубов, но и организма […]
29 профессиональных секретов красоты, которые должна знать каждая женщина. Совершенству нет предела!
У каждой женщины есть свои маленькие секреты красоты. Как сделать так, чтобы не было заметно темных кругов под глазами? Как правильно уложить волосы, чтобы они выглядели шикарно даже в конце вечеринки? Как сделать дома идеальный маникюр? Подобных вопросов, которые волнуют […]